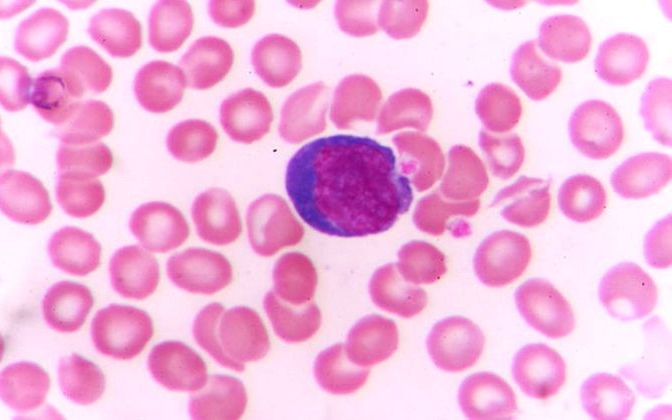
Testünk őrszemei: a gyilkos sejtek

Hírek
2016. Március 13. 12:00, vasárnap |
Helyi
Forrás: hazipatika.com
Testünk őrszemei: a gyilkos sejtek
Mi ellen harcolnak, és hogyan ölik meg a betolakodókat testünk védelmi rendszerének főszereplői, a falósejtek és az ölősejtek?
Szervezetünk belső védelmének igen fontos szereplője két agresszív sejttípus: a falósejt, más néven fagocita és a természetes ölősejt, angol nevének rövidítésével: NK sejt.
A falósejtek legtöbbje makrofág (a szó jelentése: nagyevő). A vándorló makrofágok fertőzések után nyomoznak, mikrobákkal és sejttörmelékkel táplálkoznak. A helyhez kötött makrofágok szervekben, például az agyban és a májban lakoznak. A makrofágok után szervezetünk legfontosabb falósejtjei a leggyakoribb fehérvérsejtek, a neutrofil granulociták. Az eozinofil granulociták kevésbé falánkak, de így is fontos szerepet játszanak a férgek és egyéb élősdiek elpusztításában.
A limfociták 15 százaléka természetes ölősejt. Az NK sejtek a fagocitákhoz hasonlóan a lépben, a nyirokcsomókban és a vörös csontvelőben fordulnak elő. Nagyon sokféle mikroorganizmust, sőt daganatsejteket is képesek elpusztítani. Azokat a sejteket veszik célba, amelyek felszínén gyanús fehérjéket vesznek észre.
Az NK sejtek szó szerint kilyuggatják a megtámadott mikrobákat. Speciális anyagukkal, a perforinnal lyukat ütnek rajtuk, így a sejttartalom kifolyik, a mikroba elpusztul. Az NK sejtek olyan anyagokat is kiválasztanak, amelyek programozott sejthalált váltanak ki.
Öngyilkos immunrendszer
A szerzett immunhiányos tünetegyüttes (AIDS) lényege: az immunrendszer képtelen megvédeni a szervezetet a fertőzésektől. Az 1981-ben leírt kór az egész világon ismert: 35 millió áldozatot szedett, vírusát mai ismereteink szerint 34 millióan hordozzák.
Az AIDS kórokozója, a HIV (emberi immunhiány vírus) ördögi módon önmaga ellenségévé teszi az immunrendszert. Miután behatol az immunsejtbe, ledobja védelmező fehérjeburkát, majd átállítja a sejt DNS-másoló gépezetét, saját RNS-örökítőanyagának DNS-másolatát sokszorosíttatja. A vírus-RNS DNS-másolata beépül a gazdasejt DNS-ébe, emiatt a sejt vírusok miriádjait kezdi termelni.
Az AIDS tehát nagyon gonosz betegség; ennek ellenére a betegek túlélési esélye jelentősen nőtt, amióta hatékony gyógyszer-kombinációk állnak az orvosok rendelkezésére.
Ezek érdekelhetnek még
2026. Június 19. 08:39, péntek | Helyi
A tulajdonos élőben figyelte a betörést, végül Budapesten fogták el a gyanúsítottakat
A kiskunfélegyházi tulajdonos élőben nézte végig a lopást, azonban a kamerán keresztül ráordított a betörőre, aki elszaladt. Végül a feltételezett elkövetőt és társát budapesti otthonukban fogták el a rendőrök.
2026. Június 12. 11:49, péntek | Helyi
Augusztusban érvényüket vesztik a régi, könyv formátumú személyazonosító igazolványok
2026. Június 12. 11:42, péntek | Helyi
Vasárnap országos vásár Kiskunfélegyházán
Félegyházi Városfenntartó Nonprofit Kft. Piac- és Vásárüzemeltetési részlege tájékoztatja a vásárlókat és az árusokat, hogy a Kiskunfélegyházi Országos Állat és Kirakodó vásár időpontja: 2026. június 14. (vasárnap).
2026. Június 11. 14:12, csütörtök | Helyi
Elektromos rollerek használatának korlátozását kezdeményezi a városvezetés
A tegnapi napon súlyos elektromos rolleres baleset történt a Kossuth Lajos utcán. A sérültnek ezúton is mielőbbi és teljes felépülést kívánok.
